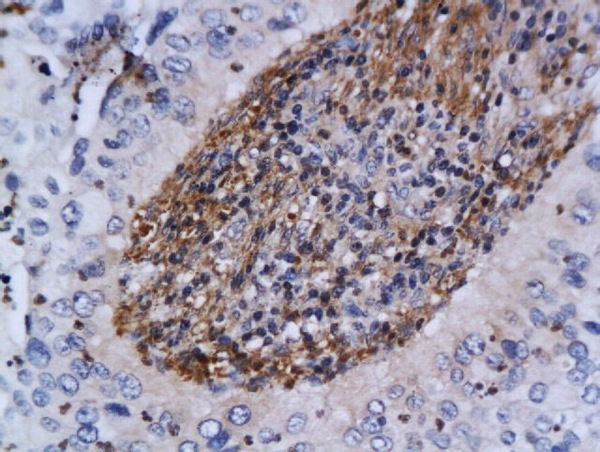
Formalin-fixed and paraffin embedded human cervical cancer labeled with Anti-ATM Polyclonal Antibody, Unconjugated (bs-1370R) at 1:200 followed by conjugation to the secondary antibody and DAB staining Formalin-fixed and paraffin embedded human cervical cancer labeled with Anti-ATM Polyclonal Antibody, Unconjugated (bs-1370R) at 1:200 followed by conjugation to the secondary antibody and DAB staining

Image provided by One World Lab validation program. A549 cells probed with Rabbit Anti-ATM Polyclonal Antibody (bs-1370R) at 1:50 for 60 minutes at room temperature followed by Goat Anti-Rabbit IgG (H+L) Alexa Fluor 488 Conjugated secondary antibody.
ATM Polyclonal Antibody
BS-1370R
ApplicationsFlow Cytometry, ImmunoFluorescence, Western Blot, ELISA, ImmunoCytoChemistry, ImmunoHistoChemistry, ImmunoHistoChemistry Frozen, ImmunoHistoChemistry Paraffin
Product group Antibodies
ReactivityHuman, Mouse, Rat
TargetAtm
Overview
- SupplierBioss
- Product NameATM Polyclonal Antibody
- Delivery Days Customer16
- ApplicationsFlow Cytometry, ImmunoFluorescence, Western Blot, ELISA, ImmunoCytoChemistry, ImmunoHistoChemistry, ImmunoHistoChemistry Frozen, ImmunoHistoChemistry Paraffin
- Applications SupplierWB(1:300-5000), ELISA(1:500-1000), FCM(1:20-100), IHC-P(1:200-400), IHC-F(1:100-500), IF(IHC-P)(1:50-200), IF(IHC-F)(1:50-200), IF(ICC)(1:50-200)
- CertificationResearch Use Only
- ClonalityPolyclonal
- Concentration1 ug/ul
- ConjugateUnconjugated
- Gene ID11920
- Target nameAtm
- Target descriptionataxia telangiectasia mutated
- Target synonymsC030026E19Rik, serine-protein kinase ATM, A-T mutated homolog, ataxia telangiectasia gene mutated in human beings, ataxia telangiectasia mutated homolog
- HostRabbit
- IsotypeIgG
- Protein IDQ62388
- Protein NameSerine-protein kinase ATM
- ReactivityHuman, Mouse, Rat
- Storage Instruction-20°C
- UNSPSC41116161
References
- Silica nanoparticle exposure inducing granulosa cell apoptosis and follicular atresia in female Balb/c mice. Liu J et al., 2018 Feb, Environ Sci Pollut Res IntRead this paper